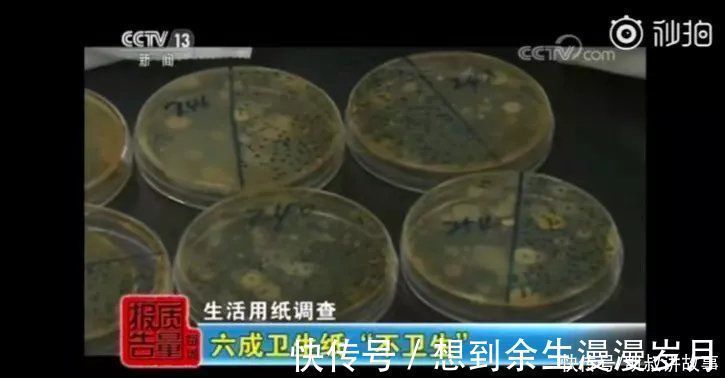
儿童|最新曝光「儿童产品黑名单」:这6样东西千万别给孩子买

儿童|最新曝光「儿童产品黑名单」:这6样东西千万别给孩子买
作者 | 典典
自从当妈后,每次带孩子出门,都会格外注意孩子的安全问题。可是,孩子在家就一定安全吗?
孩子每天吃的、穿的、用的、玩的东西,竟然都暗藏凶险,身为父母一定要当心。
今天这篇文章,给大家盘点一下央视最近两年里曝光的「儿童产品黑名单」,给大家提个醒,避免踩坑。

文章插图
每天穿的袜子,竟有致癌风险
袜子,是孩子们几乎每天都要穿的。
但你能想象吗?
买回来的「棉袜」,96%以上都是聚酯纤维,真正的棉含量是0!

文章插图
最近,央视就曝光了一批问题袜子:
江苏省市场监管总局共抽查95批袜子,其中有16批次不合格,不合格率高达17% 。
电商和直播平台抽查的20批次样品,有6批次不合格,不合格率高达30%。
(明显高于生产企业和实体店)
这些不合格袜子的问题主要在于:
纤维含量超标;
甲醛含量超标;
可分解致癌芳香胺染料超标。

文章插图
国家规定,可分解致癌芳香胺染料不得超过20毫克/千克,而抽查的一款袜子这一指标竟然高达71毫克/千克!

文章插图
染料本身很难被洗掉,这样的袜子穿在脚上,染料就会通过皮肤、呼吸道、肠胃道进入到人体,富集以后可能会致癌。
所以,建议家长在给孩子选购袜子时,选择正规渠道和大品牌,品质有保证。
千万不要为了贪便宜,购买来路不明的劣质袜子。一双袜子花不了多少钱,耽误孩子的健康就得不偿失了。

文章插图
手持小风扇,变身「小炸弹」
便携式小风扇这几年大受欢迎,由于它外观可爱,体积小,重量轻,随时随地就能吹风,深受孩子们喜爱。
但你可能不知道,小风扇虽用着方便,风险却不小。

文章插图
一些风扇的外壳缝隙较大,小一点的孩子手指是可以塞进去的,如果在风扇开着的状态下不小心被卡住,会有被内部扇叶伤到的风险。
最大的隐患来自内部电池。
国家家用电器质量检测中心,对全国7省市64家企业生产的70批次便携式电风扇产品进行测试之后,发现有17.1%的产品不合格。
实验过程中,不少劣质电池当场爆炸。部分厂家为了降低成本,使用伪劣锂电池零部件,对人体伤害等级较高。

文章插图
可想而知,如果在孩子使用过程中发生电池爆炸,轻则炸伤孩子,严重的还有可能造成火灾等严重后果。
专家建议,选购小风扇时掌握这4点:
1、切莫选购三无产品(无生产日期、无生产厂家、无质量合格证);
2、看风扇表面是否光滑平整;
3、严格按照说明书中的警告语使用;
4、充电时用原装充电设备。

文章插图
60%的卫生纸,根本不卫生
每天都在用的卫生纸,竟然不卫生?听起来简直太荒谬了。
2019年,央视曝光了一组纸品不合格数据。江苏省市场监管局共抽查150批次的纸巾纸和卫生纸产品,结果显示:
150批次的纸巾纸中,有36批次不合格,不合格率超五分之一;
21批次不合格纸巾纸中,19批次存在缺斤短两,内装量不足的情况。
15批次不合格卫生纸中,有9批次细菌菌落总数超标,占比高达60%,超国家标准的13倍!
文章插图
卫生纸不卫生,问题多出在原料上。
2019年的3·15晚会,曝光了一些不法企业生产卫生用品的真相,让人触目惊心。
正常的纸类卫生用品,是以新木浆为原料。而不法厂家为了压低成本,用的是散浆!
什么是散浆?
- 牙科器械|儿童看牙,牙科器械其实都有个好听的昵称
- 标准|寒假给小吃货买什么?国内首个儿童零食标准,按这个来买就对了
- 接种|儿童打新冠疫苗剂量需减半?没必要
- 儿童|选购儿童零食应该注意什么?
- 复姓|这么多男孩叫“婷婷”“海燕”?最新爆款名字有哪些?2021年全国姓名报告出炉
- 男孩儿|儿童身高参照表或已公布,不妨对照参考下,看看你家孩子合格没
- 博士帽|儿童牙膏怎么选?四款常见的儿童牙膏使用体验评测
- 小太阳|央视曝光“伤人暖宝宝”:睡一觉就全身变红,却有无数孩子在用
- 接种疫苗|【百年协和讲堂】一类疫苗和二类疫苗有啥区别?如何选择自费疫苗?【儿童预防接种宣传日】
- 肺炎疫苗|【百年协和讲堂】7价、13价和23价肺炎疫苗有啥不同?为啥出生后要及时打卡介苗和乙肝疫苗?【儿童预防接种宣传日】
